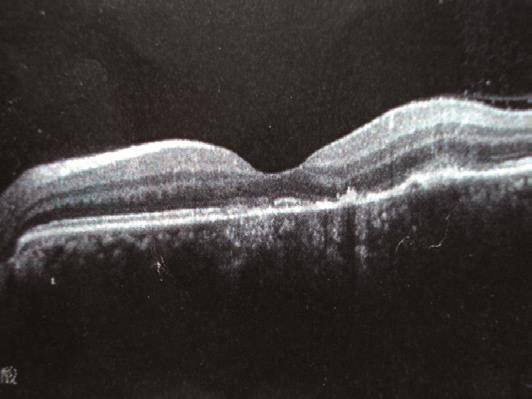

李某某,女,47岁。
2005年12月前左眼眶胀伴视力下降,当地医院眼底检查:黄斑区视网膜下渗出,FFA黄斑区渗漏,诊断为急性色素上皮炎。治疗不详。
入院前5个月,无明显原因出现左眼胀及眼前闪光,伴视力下降和视野缺损,于当地医院眼底及FFA(图1a~b)检查见(2009年9月)黄斑区偏下可见多处边界清及边界不清的高荧光区(随显影时间延长而增强),诊断为局灶性脉络膜炎,予以泼尼松治疗,症状缓解。之后激素逐渐减量至停用。此后类似症状反复发作3次,均为激素治疗有效、停药后复发。10天症状再次发作,视野缺失明显,于2010年2月来我院眼科就诊,OCT示RPE层局部凹凸不平(图2),诊断同前,疑风湿病,于2010年2月22日收入我科。

图1
a. 眼底脉络膜病变;b. FFA:左眼颞下血管弓处可见大片斑驳样高荧光,晚期视盘鼻侧边缘轻渗漏,
病变边缘荧光素轻渗漏,拱环鼻侧可见片状高荧光渗漏
图2
OCT显示RPE层局部凹凸不平
起病后,无发热、皮疹、关节痛、口腔溃疡等。
既往史:1岁时患麻疹伴右眼受累,当地医院诊断为“眼内炎”,治疗不详而放弃治疗,致失明。1984年植入义眼。5年前左眼胀伴视力下降,当地医院诊断为急性视网膜色素上皮炎,对症治疗。
查体:一般情况好,体温正常,神清语利,血压120/70mmHg,皮肤黏膜未见异常,浅表淋巴结未及肿大。右眼义眼,左眼结膜无充血及苍白。耳鼻无畸形,甲状腺无肿大,心肺肝脾未见异常,四肢关节未见异常。
化验:WBC7.54×109/L,Hb138g/L,Plt276×109/L,ESR5mm/h,RF、CRP、HLA-B27(-),PR3-ANCA 141RU/ml,MPO-ANCA(-),ANA、ENA、AKA、APF均(-),肝肾功能正常,尿RT(-),肺CT(-)。
鼻窦CT:右侧后组筛窦可见高密度影,未见气化;右上颌窦黏膜肥厚、黏膜下囊肿。
诊断:ANCA相关性系统性血管炎。
予以激素及免疫抑制剂治疗一周,脉络膜水肿有所好转,之后加用TNF抑制剂。
2周后眼科复查:脉络膜水肿病变明显好转。复查ANCA95RU/ml。
1个月后复查,病情稳定,ANCA转阴。













